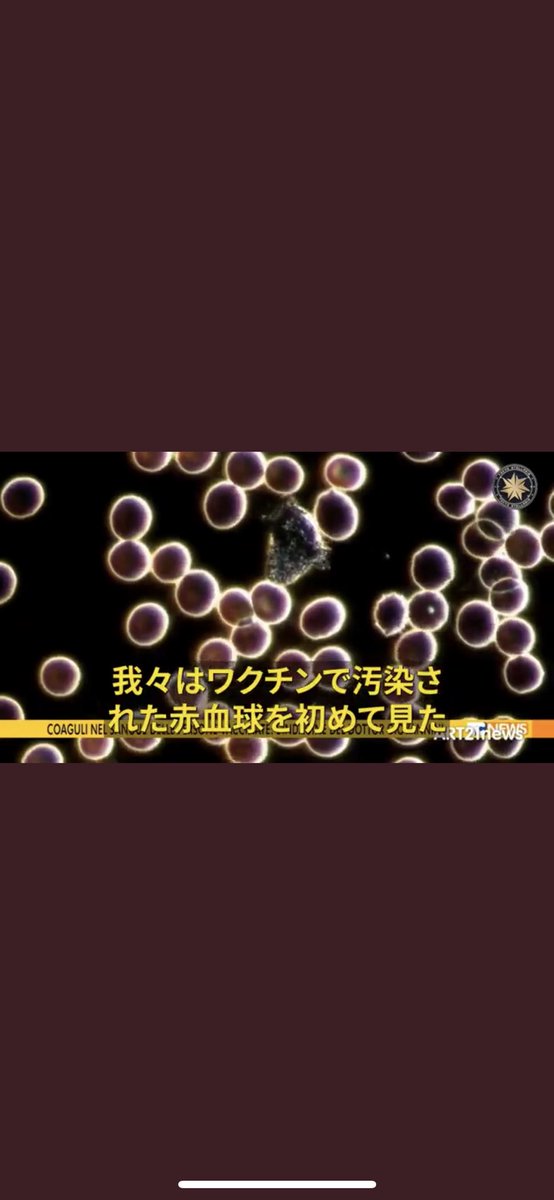

26
27
28
30
31
32
都内の山手線の通勤電車などに乗っているとワクチン3回目4回目の人達が多いのでワクチン臭の嫌な匂いと非接種の人達はシェディングを受けて喉が痛くなりますので気おつけた方が良いです。
33
34
35
36
37
38
39
40
41
42
43
44
45
46
47
48
49
50